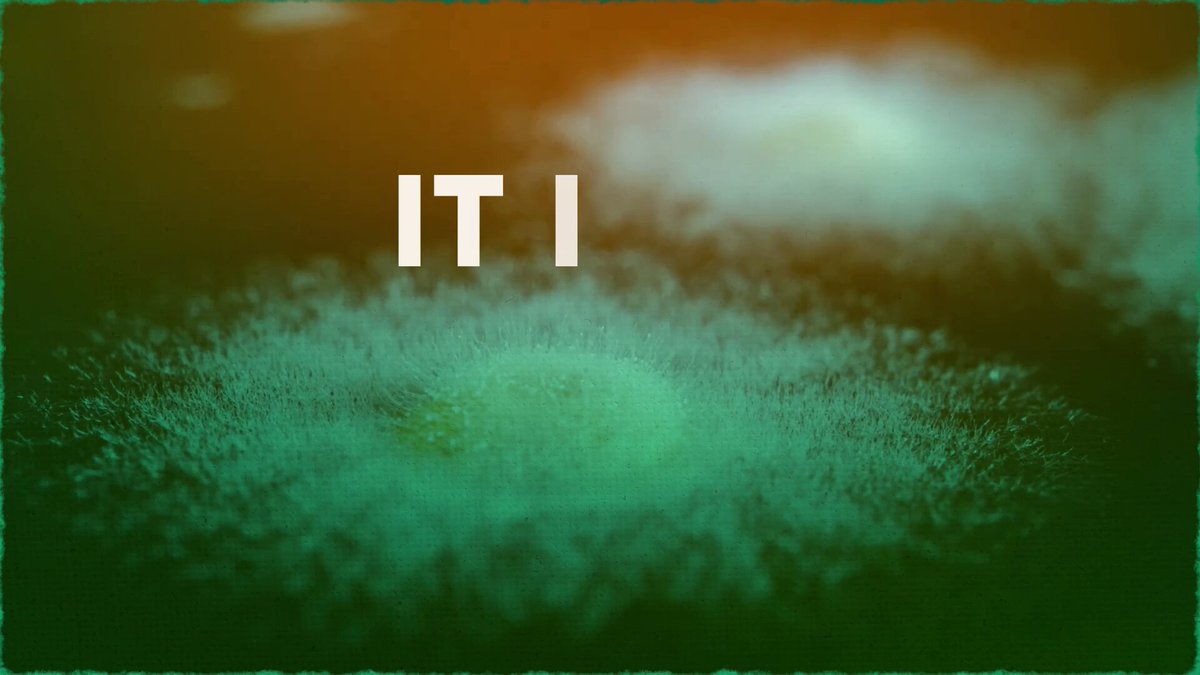

NewClaim a free social report
followers
3.75K
impressions
1.33M
likes
4.84K
comments
375
posts
238
engagement
0.393%
emv
$28.2K
Average per post
5.57K
Key Metrics
Impressions
monthly
Distributions
Content

111K
295
10
41
1mo ago
DTHshow
Soviet scientists figured out how to slow aging in 1976. The Western world ignored it for 50 years. Meanwhile, RFK just rewrote the rules on what's allowed in your syringe.
We sat down with @AbudBakri to break down why the most underrated longevity tools might be peptides nobody in your doctor's office has ever heard of.
In this episode of Down to Health, we cover:
-The real Soviet origin story behind Pinealon, Epitalon, and the bio regulators!
-Why the thymus, not your heart, might be the key to living longer?
-What the Enhanced Games are actually testing in May?
-How RFK's "peptides are supplements" call changes everything for BPC-157?
Hosted by @theNOBSdentist, @CalvinandNOBS, and @TJ_Bongiorno.
Brought to you by:
• NOBS: https://t.co/3hOXWb7Kfm
• The Outgoing Co.: https://t.co/NFbUQBzrXg
Follow @dthshow for more!

106K
513
22
59
4mo ago
DTHshow
The health advice is: eat sugar, drink coffee, get sunlight, avoid kale, skip the marathon, and eat ice cream. I've been training for this my entire life. Episode 3 is LIVE 👇 w/@alannahhello
#raypeat #bioenergetics #metabolichealth #womenshealth

106K
193
31
38
4mo ago
DTHshow
WE'RE LIVE! We broke down the current state of biohacking with Dr. @AbudBakri . We put the internet's most unhinged Biohacks on trial. Go watch! 👇
92.5K
203
10
31
2mo ago
DTHshow
Episode 10 is now LIVE!
Is the mold in your house making you sick, or is "mold toxicity" just another myth?
Together with @BioavailableNd, @NoahRyanCo and @CoffeeBlackMD, we dive deep into the fluoride-level controversy surrounding mold. To some, it’s a multi-system biotoxin that causes severe brain fog, intense allergies, and chronic fatigue. To others, it's completely overblown because we breathe in mold spores every single day. From brain fog and existential dread to the medical skepticism surrounding it, we cover it all!
GO WATCH! 👇

75.6K
221
31
32
2w ago
DTHshow
You don't need to be maxxing. You need to be balancing.
We sat down with @BowTiedPhys, the self-taught voice behind the Bow Tied community here on X, to unpack why the maxing era of health content is a trap and why learning how to think beats every protocol on your timeline.
In this episode of Down to Health:
-The "Psyop Audit" of the internet's most repeated health takes!
-The deep cut that tanked his own hormones!
-Why thinking like an engineer is the real superpower in digital health!
Hosted by @theNOBSdentist, @CalvinandNOBS, and @TJ_Bongiorno.
Brought to you by:
NOBS: https://t.co/3hOXWb7Kfm
The Outgoing Co.: https://t.co/NFbUQBzrXg
Follow @dthshow for more!

62.6K
204
10
24
3mo ago
DTHshow
Episode 8 is LIVE!
In this episode of Down to Health, guests naturopath @BioavailableNd and fertility specialist @DrRobKiltz expose their theories on how environmental toxins and modern diets drive widespread infertility. Go watch! 👇

48.8K
37
12
6
4mo ago
DTHshow
Bears eat salmon to hibernate. You're not a bear.
#omega3truth #raypeat #metabolismhacks #salmonmyth

46.9K
95
19
24
4mo ago
DTHshow
Our first ever episode is going live TODAY!
We invited our good friend, Dr. @AbudBakri, to break down the current state of biohacking with us.
It was a wild one.
See you at 3pm EST! 👇

41.2K
98
5
17
3mo ago
DTHshow
Episode 6 is LIVE!
In this episode, we sit down with Dr. Valerie Kanter, a board-certified endodontist and co-founder of the Institute of Functional Dentistry, to dismantle the "Root Cause" controversy. We dive into why traditional 2D X-rays often miss chronic, silent infections and how new 3D technology is uncovering the truth about oral health.

29.3K
49
0
5
4mo ago
DTHshow
Ray Peat never wrote a diet. People invented one anyway. w/
@alannahhello
#raypeat #cravings #intuitiveeating #metabolism

25.9K
42
4
12
2mo ago
DTHshow
Episode 9 is LIVE!
America used to make its own creatine. Now China owns 90% of the market. We called @AJA_Cortes who's bringing it back home.
In this episode: the geopolitics behind your pre-workout, why most gummies are a scam, and why your doctor might be prescribing this stuff within 2 years.
GO WATCH!👇

24.6K
31
3
7
1mo ago
DTHshow
Peptides were once the best-kept secret of the powerlifting community. Today, they’ve hit the mainstream.
Here’s how the explosion of GLP-1s changed the public's comfort level with research-grade compounds.
Catch the full episode here or YouTube: DTHshow

20.1K
30
1
10
2mo ago
DTHshow
Your Apple Watch is lying to you about your VO2 Max. And no, lifting is not your cardio. 📉
We sat down with exercise researcher @Brady_H to break down the one metric that quietly controls your entire fitness ceiling: VO2 max.
In this episode of Down to Health, we cover:
⌚ Why your wearable is giving you fake VO2 max scores
🏃♂️ How to actually improve your cardiovascular fitness at any age
🚶♂️ The BS behind the 10,000 steps rule
🏋️♂️ Why cardio actually does not kill your gains
Hosted by @theNOBSdentist, @CalvinandNOBS, and @TJ_Bongiorno.
🤝 Brought to you by:
• NOBS: https://t.co/3hOXWb8i4U
• The Outgoing Co.: https://t.co/NFbUQBzZMO
Follow @dthshow for more! 🎙️

19.3K
75
9
21
1w ago
DTHshow
Everything on this table, the big companies are going to try to replicate in 3 to 5 years.
No guest, no script, nobody paid us a dime. Just the three of us and a table full of the health products we actually reach for when the cameras are off, and we got way too excited about all of them.
In this episode of Down to Health:
• The olive oil that ruins every other olive oil for you!
• The methylene blue that had the whole internet calling us idiots!
• The black seed oil that tastes like pure gasoline (and we drink it anyway)!
Some of these founders are our friends. Most have no idea we're even doing this. The only brands we're tied to are the ones we built ourselves.
Hosted by @theNOBSdentist, @CalvinandNOBS, and @TJ_Bongiorno.
Brought to you by:
NOBS: https://t.co/3hOXWb7Kfm
The Outgoing Co.: https://t.co/NFbUQBzrXg
Follow @dthshow for more!

19.0K
31
5
15
2mo ago
DTHshow
Are you secretly already in midlife? 📉
We brought on Dr. Sandeep Palakodeti to filter out the noise on what it actually takes to optimize your health as you age, no neuroticism required.
In this episode of Down to Health, together with @DrDeepMD we break down the "midlife reset" and cover:
🩸 Why standard lab reference ranges are actually failing you
🏃♂️ The marathon runner heart attack paradox 🔥 The real truth behind "inflammaging"
💤 The 3 2 1 Sleep Rule for vagal tone
Down to Health is the intelligent filter between cutting edge research, fringe communities, and the person who wants a life instead of an unhealthy obsession. Hosted by @theNOBSdentist, @CalvinandNOBS, and @TJ_Bongiorno.
Brought to you by:
• NOBS: https://t.co/qclN1wz4O1
• Outgoing Co.: https://t.co/NFbUQBzrXg
Follow @dthshow for more! 🎙️

18.3K
58
6
14
3mo ago
DTHshow
Episode 5 is LIVE! 👇
Today, we break down the real science behind cavities, mouthwash, veneers, charcoal toothpaste, fluoride, and what your mouth actually reveals to a trained eye. Whether you floss daily or haven't in months, this episode recalibrates everything you thought you knew about your teeth.

17.8K
92
9
5
4mo ago
DTHshow
Bought the wrong peptides and got darker without length benefits... 😢

17.8K
81
16
18
4mo ago
DTHshow
We sat down with @AntiDoc to break down every class of PEDs. We share our own TRT journeys and talk about the stack high performers won't admit to. Go watch! 👇

14.0K
26
1
6
9h ago
DTHshow
The enhancement economy is here, and you're already living in it. We're no longer interested in being biologically normal. The question isn't whether you enhance, it's whether you do it with real information.
This episode is a collaboration with @DrAlexTatem, urologist and one of the sharpest voices on what this new economy looks like from inside the clinic.
In this episode of Down to Health:
-Why "enhancement" is no different from taking your blood pressure meds
-The 2023 FDA ban that stripped peptide access overnight, and the July vote to bring it back
-When you actually get OFF a stack, the question nobody's asking
You can leave a public comment on the peptide reinstatement RIGHT NOW as a private citizen: https://t.co/dsQMZYCVzI
Dr. Tatem's new merch line is live: https://t.co/escdRtUAzy
More from him: https://t.co/3JtZK4DNxR
Hosted by @theNOBSdentist, @CalvinandNOBS, and @TJ_Bongiorno.
Brought to you by:
NOBS: https://t.co/3hOXWb7Kfm
The Outgoing Co.: https://t.co/NFbUQBzrXg
Follow @dthshow for more!

13.8K
39
1
10
1mo ago
DTHshow
A French kid grew up climbing boulders outside Paris. 50 years later, he holds a U.S. record for holding his breath nearly 7 and a half minutes, and he's convinced your gym is making you weaker.
We sat down with @ErwanLeCorre to expose why the most underrated longevity tool is something every toddler already does better than you.
In this episode of Down to Health:
-The truth behind Zoo Human Syndrome (and why you probably have it)!
-Why breath holding is a full nervous system rewrite?
-The protocol that dropped Calvin's heart rate 10 points on camera?
Hosted by @theNOBSdentist, @CalvinandNOBS, and @TJ_Bongiorno.
Brought to you by:
NOBS: https://t.co/3hOXWb7Kfm
The Outgoing Co.: https://t.co/NFbUQBzrXg
Follow @dthshow for more
Down To Health (@dthshow) X Stats & Analytics
Down To Health (@dthshow) has 3.75K X followers with a 0.39% engagement rate over the past 12 months. Across 238 posts, Down To Health received 4.84K total likes and 1.33M impressions, averaging 20.3 likes per post. This page tracks Down To Health's performance metrics, top content, and engagement trends — updated daily.
Down To Health (@dthshow) X Analytics FAQ
How many X (Twitter) followers does Down To Health have?+
Down To Health (@dthshow) has 3.75K X (Twitter) followers as of June 2026.
What is Down To Health's X (Twitter) engagement rate?+
Down To Health's X (Twitter) engagement rate is 0.39% over the last 12 months, based on 238 posts.
How many likes does Down To Health get on X (Twitter)?+
Down To Health received 4.84K total likes across 238 posts in the last 12 months, averaging 20.3 likes per post.
How many X (Twitter) impressions does Down To Health get?+
Down To Health's X (Twitter) content generated 1.33M total impressions over the last 12 months.